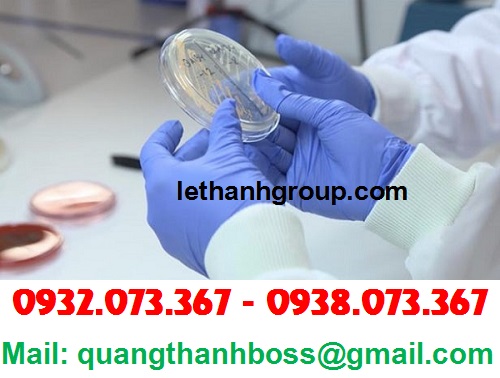

MUA GIÁ RẺ GĂNG TAY TT XANH, TRẮNG 3.5G DÙNG TRONG PHÒNG THÍ NGHIỆM
***
CÁC SẢN PHẨM GĂNG TAY CÔNG TY LÊ THANH ĐANG SẢN XUẤT
♦♦♦
1* Găng tay len muối tiêu 40g, 50g, 60g, 70g, 80g
2* Găng tay len trắng kem 40g, 50g, 60g, 70g, 80g
3* Găng tay len xám đen 40g, 50g, 60g, 70g, 80g
4* Găng tay len poly trắng 40g, 50g, 60g, 70g, 80g
5* Găng tay vải thun cotton các loại
6* Găng tay len nhúng nhựa 40g, 50g, 60g,70g, 80g
7* Găng tay len hạt nhựa 40g, 50g, 60g, 70g, 80g
11* Găng tay vải mỏng các loại
13* Găng tay cao su gia dụng, công nghiệp, đa năng
14* Găng tay xốp, dẻo các loại
15* Găng tay phủ PU chống tĩnh điện các loại
16* Găng tay chống cắt các loại
18* Thảm nỉ các loại
Mời quý khách click vào đây để xem thêm video & tin tức các sản phẩm khác của Công ty
Đặc điểm của găng tay dùng trong phòng y tế
Mua giá rẻ găng tay TT xanh, trắng 3.5g dùng trong phòng thí nghiệm là nhu cầu cần thiết của con người. Loại sản phẩm này có vai trò vô cùng quan trọng, vừa đảm bảo an toàn sức khỏe lại quyết định đến sự thành công của thí nghiệm. Trong phòng thí nghiệm thường có nhiều hóa chất, các hóa chất ấy nếu không may bị đổ ra tay có thể dẫn đến những hậu quả khó lường, hơn thế sản phẩm này không thể tái sử dụng nhiều lần nên khả năng tiêu thụ của chúng ngày càng cao hơn.
Găng tay TT của công ty Lê Thanh được sản xuất bởi những nguyên liệu cao cấp nhất nên sản phẩm không những an toàn cho da mà còn đảm bảo độ bền lâu cho người sử dụng, không dễ rách, dai và bám chặt vào tay sẽ giúp bạn thực hiện công việc được dễ dàng hơn. Đặc biệt khi đến với công ty chúng tôi, quý khách hàng sẽ có cơ hội mua được những sản phẩm cao cấp với mức giá thành rẻ nhất.
Găng tay TT chất lượng cao, không có các chất kích thích gây hại hay gây hiệu ứng cho da. Độ dai và khả năng đàn hổi tốt nên chịu được các lực kéo dãn mà ít khi bị rách hay bị biến dạng khi sử dụng. Nhờ có điều đó mà con người có thể thoải mái và cảm thấy thật tay hơn khi sử dụng sản phẩm này.
Mua găng tay phòng thí nghiệm giá rẻ ở đâu?
Nếu bạn muốn tìm mua giá rẻ găng tay TT xanh, trắng 3.5g dùng trong phòng thí nghiệm thì đừng quên liên hệ công ty Lê Thanh nhé! Công ty Lê Thanh là đơn vị hàng đầu chuyên sản xuất găng tay cao su trắng, xanh trong phòng thí nghiệm, phòng y tế....
Công ty Lê Thanh chuyên sản xuất các sản phẩm găng tay chất lượng cao, nên dù là găng tay loại nào chúng tôi cũng có thể cung cấp cho quý khách. Găng tay TT dùng trong phòng y tế có các màu: trắng, xanh, đen. Tùy thuộc vào nhu cầu sử dụng mà quý khách hàng có thể lựa chọn màu cho phù hợp.
Công ty Lê Thanh phân phối găng tay TT trong phòng thí nghiệm bằng tất cả trách nhiệm và sự uy tín của mình trong nhiều năm qua. Hãy nhấc máy lên và liên hệ với chúng tôi qua SĐT: 0932.073.367 - 0938.073.367 để được tư vấn nhé!
Mời quý khách click vào đây để xem thêm video & tin tức các sản phẩm khác của Công ty
Nơi chuyên sản xuất găng tay, bao tay len bảo hộ lao động 40g, 50g, 60g, 70g, 80g. Xưởng sản xuất, chuyên phân phối găng tay bảo hộ lao động. Cần mua găng tay bảo hộ lao động số lượng lớn, giá rẻ. Găng tay, bao tay 100% cotton. Sản xuất găng tay, bao tay thun Cotton theo yêu cầu. Tìm mua găng tay, bao tay đen, muối tiêu chống cắt. Bán găng tay Pu phủ bàn xám có viền, không viền. Bao tay, găng tay phủ ngòn Pu nhiều size S, M, L. Sản xuất, phân phối găng tay chống tĩnh điện. Mua găng tay, bao tay chống tĩnh điện. Găng tay nhúng nhựa, hạt nhựa cho nhà phân phối. Tìm nhà sản xuất và mua găng tay hạt nhựa, nhúng nhựa 40g, 50g, 60g, 70g. Nhận sản xuất bao tay vải mỏng tại xưởng theo đơn. Xưởng cung cấp găng tay vải mỏng chất lượng. Nơi cung cấp găng tay thời trang toàn quốc. Nhà cung cấp găng tay cao su giá rẻ. Chuyên sỉ găng tay cao su. Găng tay xốp cho nam và nữ. Cung cấp găng tay xốp giao hàng tận nơi. Găng tay nylong dùng cho thực phẩm. Găng tay nhập khẩu Malaysia chính hãng. Gía găng tay y tế TT Gloves đủ màu. Xưởng sản xuất găng tay y tế đen Black. Nơi mua thảm nỉ, thảm lông thú uy tín.

Xem thêm